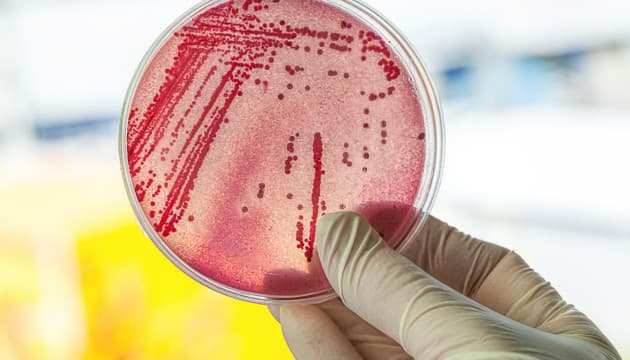

Ötzi es el nombre de una de las momias más famosas, y probablemente más investigadas, del mundo. Se trata del cuerpo congelado de un hombre que habría vivido hace unos 5300 años. La momia fue descubierta a principios de los 90 por dos alpinistas alemanes en la zona de los Alpes que se encuentra en la frontera entre Italia y Austria.
Nuevos análisis revelan que Ötzi, el hombre de hielo, tiene algo que decirnos sobre la migración europea

Su descubrimiento supuso una rara oportunidad de analizar un cuerpo de esa edad tan bien conservado y los científicos no la dejaron pasar. Desde entonces, Ötzi se ha convertido en uno de lo s pacientes más investigados del mundo y nos ha proporcionado con muchas pistas valiosas sobre la vida en la Europa antigua. Afortunadamente, todavía tiene mucho para decirnos y los científicos han anunciado un descubrimiento que nos ayuda a entender cómo se sucedieron las migraciones de poblaciones europeas.
- Ver también: «9 momias sorprendentemente conservadas y un poco aterradoras»
¿Quién era Ötzi?

Los expertos también han podido averiguar mucho sobre quién era este misterioso « hombre de hielo». En primer lugar, saben que vivió alrededor del 3300 a. E. C. Tenía ojos marrones, varios tatuajes, era intolerante a la lactosa y vivía en una comunidad que, hoy en día, estaría relacionada con los sardos.
Al momento de su muerte, habría tenido entre 40 y 50 años. Su muerte, precisamente, es uno de los hechos más conocidos sobre Ötzi. Habría muerto asesinado: los expertos encontraron lo que sería una punta de flecha en su pulmón izquierdo.
Por muchos años, los expertos intentaron además descubrir cuál había sido la última cena de Ötzi, pero su estómago estaba vacío, lo cual generó bastante confusión entre los investigadores. Esto es, hasta que notaron que lo que estaban analizando era el colon, el estómago había sido desplazado, probablemente por efecto del hielo.
Habiendo identificado el órgano correcto, los expertos lograron encontrar rastros de alimentos. Aunque estos todavía no han arrojado resultados definitivos, el estómago de Ötzi contenía algo más, algo que podría ayudarnos a comprender la historia de las poblaciones europeas.
- Ver también: «Ötzi, el hombre de hielo más famoso del mundo»
Helicobacter pylori
Probablemente haya sido la menor de las preocupaciones para Ötzi, pero, además de la flecha, otro intruso estaba afectando su salud. Se trataba de la Helicobacter pylori, una bacteria muy común que la mitad de la población tiene en su estómago y en algunos casos puede causar úlceras y otros problemas estomacales.
Una mala noticia para Ötzi, pero una muy buena para los científicos, quienes no perdieron la posibilidad de analizarla. Helicobacter pylori lleva miles de años con los humanos y la variedad que se encuentra actualmente en los estómagos europeos parece ser una combinación de bacterias llevadas a Europa por poblaciones asiáticas y africanas.
Al analizar la bacteria encontrada en el hombre de hielo, los expertos concluyeron que se correspondía con una variedad proveniente del centro y sur de Asia, sin rastro alguno de la variedad africana. Esto implica que habría existido una ola migratoria africana hacia Europa, la cual llevó consigo su propia variedad de Helicobacter pylori. Esta ola, claro está, tendría que haber sucedido después de la vida de Ötzi, algo que hasta ahora los expertos no sabían.
¿Conocías la historia de Ötzi? ¿Qué otras pistas crees que nos podrá proporcionar en el futuro?
- También te puede interesar: «Descubrimientos arqueológicos muy perturbadores»










